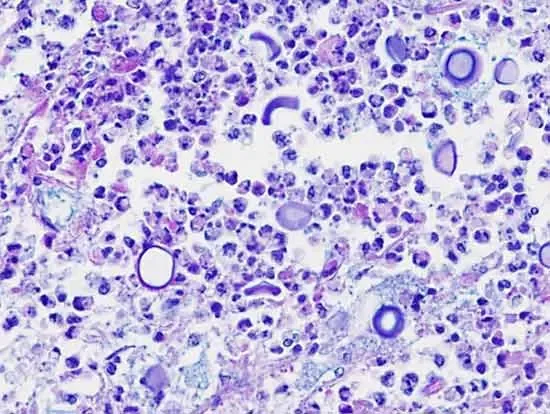

Atypical Cutaneous Fungal Infections: Cryptococcus
Cryptococcus is a genus of encapsulated environmental yeasts (mainly Cryptococcus neoformans and the C. gattii complex) that can infect animals—most commonly cats and dogs—usually after inhalation of contaminated soil, decaying wood, or bird droppings or by direct skin inoculation. In animals, it most often causes chronic nasal disease (sneezing, nasal discharge, depigmentation, or nodules on the nasal planum) or cutaneous nodules and ulcers, and it can disseminate to the lungs, eyes, and the central nervous system. Diagnosis relies on cytology/histopathology, fungal culture, and serum cryptococcal antigen testing; treatment requires prolonged systemic antifungal therapy (often fluconazole or itraconazole), sometimes combined with surgical debulking and monitoring for relapse.
Why is Cryptococcus important to the Region?
Cryptococcus infections occur worldwide, but their distribution is not uniform. In many regions cryptococcal disease is uncommon — and it’s less frequently reported in the Mid‑Atlantic than in classic endemic areas. Because of that, clinicians and owners in this region may not immediately consider fungal causes for persistent nasal or cutaneous nodules.
Key Characteristics of Cryptococcus
Nasal: sneezing, nasal discharge, depigmentation or ulceration of the nasal planum, or nodular masses on the nose.
Cutaneous: solitary or multiple nodules, ulcerations, or draining tracts — may be primary (direct inoculation) or secondary to dissemination.
Systemic: lungs, eyes, and CNS can be involved when the infection disseminates.
Lesion Appearance: Lesions are often chronic and granulomatous and may not respond to routine antibiotics or topical steroid creams.
Itching: Pruritus is usually low or absent unless there is secondary irritation.
Fred’s Case: Feline Cryptococcus Diagnosis
Fred is a 2‑year‑old neutered male tabby adopted in December 2024. He arrived at his new home happy and healthy. In May 2025 his owner noticed two small, raised nodules on the nasal planum. Topical Animax ointment was applied twice daily without improvement. By August, Fred was evaluated at Mid‑Atlantic Veterinary Dermatology and biopsies were submitted. Histopathology described multifocal, raised, nodular, pyogranulomatous and lymphoplasmacytic dermatitis with intralesional encapsulated yeasts and superficial serocellular crust — consistent with cryptococcosis. He was rechecked in October with clinical monitoring and ongoing treatment.
Fred’s diagnostic workup
History: Nodules first seen May 2025; no lesions at adoption in December 2024. No systemic signs reported. Owner reports topical Animax used without improvement.
Biopsy (August 2025): Pyogranulomatous and lymphoplasmacytic dermatitis with encapsulated yeasts — consistent with Cryptococcus. Special stains (mucicarmine, PAS, or GMS) typically highlight the capsule/yeast cells on histology.
Recommended complementary tests (if not already completed): fungal culture to identify species (C. neoformans vs C. gattii complex), serum cryptococcal antigen (CrAg) for screening or monitoring, baseline CBC and biochemistry before systemic antifungal therapy, FeLV/FIV testing, and thoracic imaging if respiratory signs or concern for dissemination.
We are excited to share before and after photos of Fred’s case to highlight the dramatic improvement possible with correct diagnosis and treatment.
August 2025
October 2025
Clinical Treatment and Monitoring
Systemic antifungal therapy is the foundation of treatment. Common options:
Fluconazole — frequently used for nasal and cutaneous disease because of good tissue and CNS penetration and generally favorable safety.
Itraconazole — effective for some cases but requires monitoring of hepatic function.
Amphotericin B — reserved for severe or refractory disease; administered IV with careful monitoring for nephrotoxicity.
Surgical debulking can be useful for accessible nodules and may speed resolution when combined with antifungals.
Duration: Treatment is commonly prolonged (months). Continue until clinical resolution and preferably until serum antigen testing is negative (if it was positive initially) — then treat for several months beyond clearance to reduce relapse risk.
Monitoring: Serial physical exams and photographs to document lesion regression, periodic bloodwork to monitor organ function during azole therapy, and serial CrAg testing when applicable.
Implications for Veterinarians and Pet Owners
Atypical fungal infections that are uncommon in our region are frequently overlooked by clinicians, but targeted testing and special histologic stains can reveal the cause when you know what to look for. Don’t exclude fungal disease simply because your practice is outside classic endemic areas — obtaining a thorough environmental history, including any past outdoor exposures before adoption, can provide important clues.
When lesions persist or fail to respond to topical or antibacterial therapy, early biopsy and histopathology are valuable. Use cryptococcal antigen testing and fungal culture when possible to help determine prognosis and guide treatment duration. Finally, communicate clearly with clients: antifungal treatment usually takes months, requires monitoring, and, with appropriate therapy, the prognosis for cutaneous or nasal cryptococcosis is generally good.